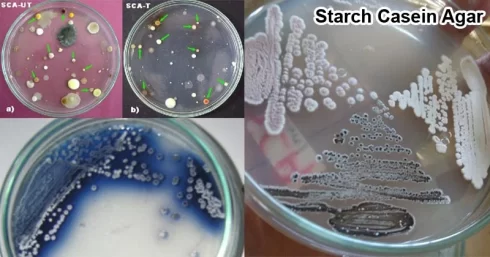
نشاسته کازئین آگار

مقدمهای بر آگار SCA (نشاسته کازئین آگار)
نشاسته کازئین آگار (Starch Casein Agar) یا آگار SCA، برای تشخیص باکتریهای دریایی ساکارولیتیک و بیشتر اکتینومیستها استفاده میشود. اکتینومیستها یک باکتری قارچ مانند هستند که رشتههای بلندی را تشکیل میدهند که در خاک کشیده میشوند. این باکتریها شامل گروه بزرگی از باسیلهای رشتهای گرم مثبت و یا شاخهای هستند.
منشأ اکتینومیستها از منابع زمینی است، البته اولین گزارش از اکتینومیستهای تشکیلدهنده میسلیوم چندین دهه پیش و از رسوبات دریایی بازیابی شده بود.
رسوبات دریایی منابع بالقوه شناخته شدهای برای جداسازی اکتینومیستهای جدید هستند که محصولات جدیدی تولید میکنند و به عنوان منبع آنتی بیوتیکها و عوامل ضد سرطان جدید شناخته میشوند. اکتینومیستها با تجزیه و تبدیل طیف گستردهای از بقایای آلی پیچیده، تأثیر گستردهای بر محیط دارند.
بنابراین، اکتینومیستها نشان دهنده گروه مهمی از میکروبهای موجود در محیط هستند و نهتنها در کاربردهای درمانی؛ بلکه در بازیافت مواد آلی نیز نقش مهمی ایفا میکنند.
ترکیبات نشاسته کازئین آگار
|
ترکیبات |
گرم / لیتر |
|
نشاسته محلول |
10.00 |
|
کازئین (بدون ویتامین) |
0.30 |
|
KNO3 |
2.00 |
|
MgSO4.7H2O |
0.05 |
|
K2HPO4 |
2.00 |
|
NaCl |
2.00 |
|
CaCO3 |
0.02 |
|
FeSO4.7H2O |
0.01 |
| آگار |
18.00 |
آب مقطر = ۱۰۰۰ میلیلیتر
pH (در 25 درجه سانتیگراد) = 0.1 ± 7.0
ترکیب نشاسته کازئین آگار HIMEDIA
|
ترکیبات |
گرم / لیتر |
|
پودر کازئین |
1.00 |
|
نشاسته |
10.00 |
|
آب دریا (به دلیل نمک موجود) |
37.00 |
| آگار |
15.00 |
آب مقطر = ۱۰۰۰ میلیلیتر
pH (در 25 درجه سانتیگراد) = 0.2±7.2
اساس نشاسته کازئین آگار
این محیط کشت دارای نشاسته به عنوان منبع کربوهیدرات پیچیده و کازئین به عنوان منبع نیتروژن است. نمکهای آب دریا منابع یونی پیچیدهای را فراهم میکنند که محیط را برای فلور میکروبی دریایی مناسب میکند و همچنین محیط را بافر میکند.
موارد استفاده از آگار SCA
- برای شناسایی باکتریهای ساکارولیتیک دریایی استفاده میشود.
- برای جداسازی اکتینومیستها استفاده میشود.
تهیه نشاسته کازئین آگار
- ۶۳٫۰ گرم نشاسته کازئین آگار را در ۱۰۰۰ میلیلیتر آب مقطر حل کنید.
- محیط کشت را حرارت دهید تا به جوش آید و کاملاً محلول شود.
- محیط را با اتوکلاو کردن با فشار ۱۵ پوند (۱۲۱ درجه سانتیگراد) به مدت ۱۵ دقیقه استریل کنید.
- سپس به خوبی مخلوط کنید و در پلیت پتریهای استریل بریزید.
تفسیر نتایج در مورد آگار SCA
اکتینومیستها: پودر مایل به سفید تا زرد همگن با جریان آزاد.
جهت خرید و یا استعلام قیمت با ما تماس بگیرید یا در واتسپ پیام بزارید
همچنین بخوانید:
- آگار ستریماید (Cetrimide Agar): ترکیب، اساس، کاربردها، آماده سازی و مورفولوژی کلنی
- تست هیدرولیز نشاسته: اصول، روش، موارد استفاده و تفسیر
مترجم: مریم محجوب



